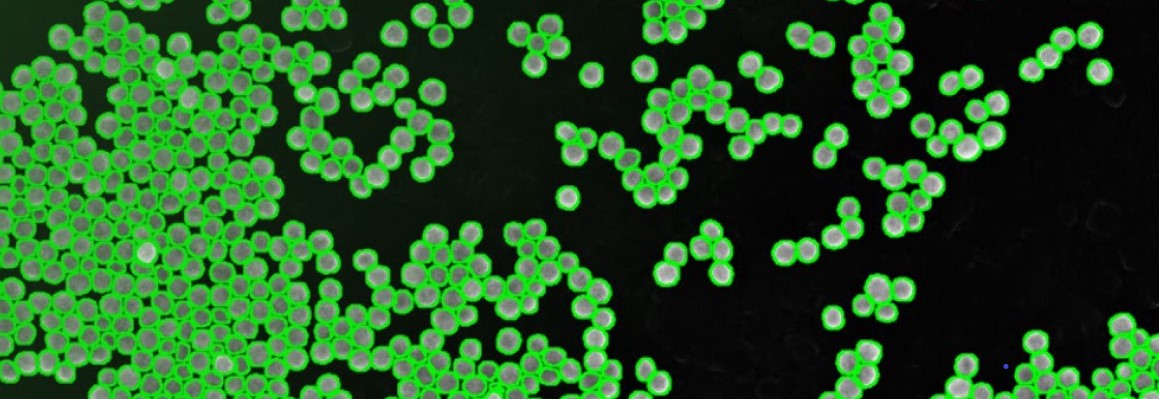
Eisenoxid Nanowürfel

Digitale Info-Tage „Nano or not Nano“
Digitale Info-Tage „Nano or not Nano“
Messen nach OECD Test Guideline No. 125
Digitale Info-Tage „Nano or not Nano“
Messen nach OECD Test Guideline No. 125
Nanomaterialien: Welche Methoden sind zur Partikelgrößenbestimmung geeignet?
Physikalisch-chemische Prüfungen basieren auf den Anforderungen aus Anhang VII der REACH Verordnung (EG) Nr. 1907/2006. Im Zusammenhang weiterer Prüfanforderungen ist es wichtig zu wissen, ob Ihre Chemikalien die Kriterien für „Nano or not Nano“ erfüllen.
Die OECD hat am 30.06.2022 eine neue Test Guideline No. 125: „Nanomaterial Particle Size and Size Distribution of Nanomaterials“ veröffentlicht. Zudem hat die Europäische Kommission eine neue Empfehlung für die Definition von Nanomaterialien erarbeitet.
Die OECD Test Guideline No. 125 listet sieben Methoden zur Bestimmung der Partikelgröße und Größenverteilung von annähernd sphärischen Nanopartikeln auf. Nicht jede Methode ist für jedes Material und für jeden Anwendungsfall geeignet. Gerade für KMUs ist es häufig schwierig, die geeigneten Testmethoden bzw. -verfahren auszuwählen und korrekt einzusetzen. Für die Registrierung nach der REACH-Verordnung ist es erforderlich Nano-Partikel in Ihren Produkten verlässlich zu identifizieren, zu klassifizieren und auszuweisen. Die Auswahl ungeeigneter Messmethoden kann zu einem falsch charakterisiertem Produkt führen wodurch die Pflichten zur Erfüllung der Anforderungen z. B. von REACH unzutreffend erfüllt werden. Unser digitaler Infotag soll Ihnen daher grundlegendes Wissen über die Möglichkeiten und Grenzen der Methoden nahe bringen und die richtige Methodenauswahl vermitteln bzw. erleichtern.
Weitere Informationen
Inhalte
Folgende Methoden wollen wir Ihnen vorstellen:
Tag 1
- Definition Nanomaterial und EU REACH: Kontext und Hintergrund
- OECD Test Guideline No. 125
- Exkurs Partikelgrößenverteilungen: Unterschiede zwischen anzahl-, volumen- und intensitäts-basierten Verteilungen
- (Nano)Partikel-Tracking-Analyse (PTA/NTA)
- Dynamische Lichtstreuung (DLS)
Tag 2
- Transmissions- und Rasterelektronenmikroskopie (REM/TEM)
- Raster-Kraftmikroskopie (AFM)
- Differentielles-Mobilitäts-Analyse-System (DMAS)
- Zentrifugale Flüssig-Sedimentationsanalyse (CLS)
- Röntgenkleinwinkelstreuung (SAXS)
- Überführung der Messdaten: Sicherheitsdatenblatt bzw. IUCLID
Zielgruppen
Der Infotag richtet sich hauptsächlich an Teilnehmende, die sich einen Überblick zu den Methoden der OECD Test Guideline No. 125 verschaffen wollen und mit EU-Vorschriften (REACH, CLP, Biozide, etc.) zu Nanomaterialien zu tun haben.
Hinweise
- Die Veranstaltung findet digital statt (Webex).
- Die Teilnahme ist kostenlos.
- Veranstaltungssprache ist Deutsch.
- Datum und Zeiten: 16.02.2023 15:00-17:00 Uhr; 17.02.2023 09:00-13:00 Uhr

Messen nach OECD Test Guideline No. 125
Weitere Angebote
Bundesanstalt für Materialforschung und -prüfung (BAM)
Herr Dr. rer. nat. Harald Bresch
Fachbereich 4.2 Material-Mikrobiom Wechselwirkungen
Frau Dr.-Ing. Vasile-Dan Hodoroaba
Leitung Fachbereich 6.1 Oberflächenanalytik und Grenzflächenchemie
Frau Dipl.-Ing. Petra Kuchenbecker
Fachbereich 5.4 Multimateriale Fertigungsprozesse
Frau Dr. Brian Pauw
Fachbereich 6.5 Synthese und Streuverfahren nanostrukturierter Materialien
Frau Dr. rer. nat. Petra Schulte
Fachbereich 2.2 Prozesssimulation
Frau Prof. Dr. rer. nat. Heinz Sturm
Leitung Fachbereich 6.6 Physik und chemische Analytik der Polymere
stellvertetende Leitung Fachbereich 6.5 Synthese und Streuverfahren nanostrukturierter Materialien
Frau Dr. rer. nat. Isabella Tavernaro
Fachbereich 1.2 Biophotonik